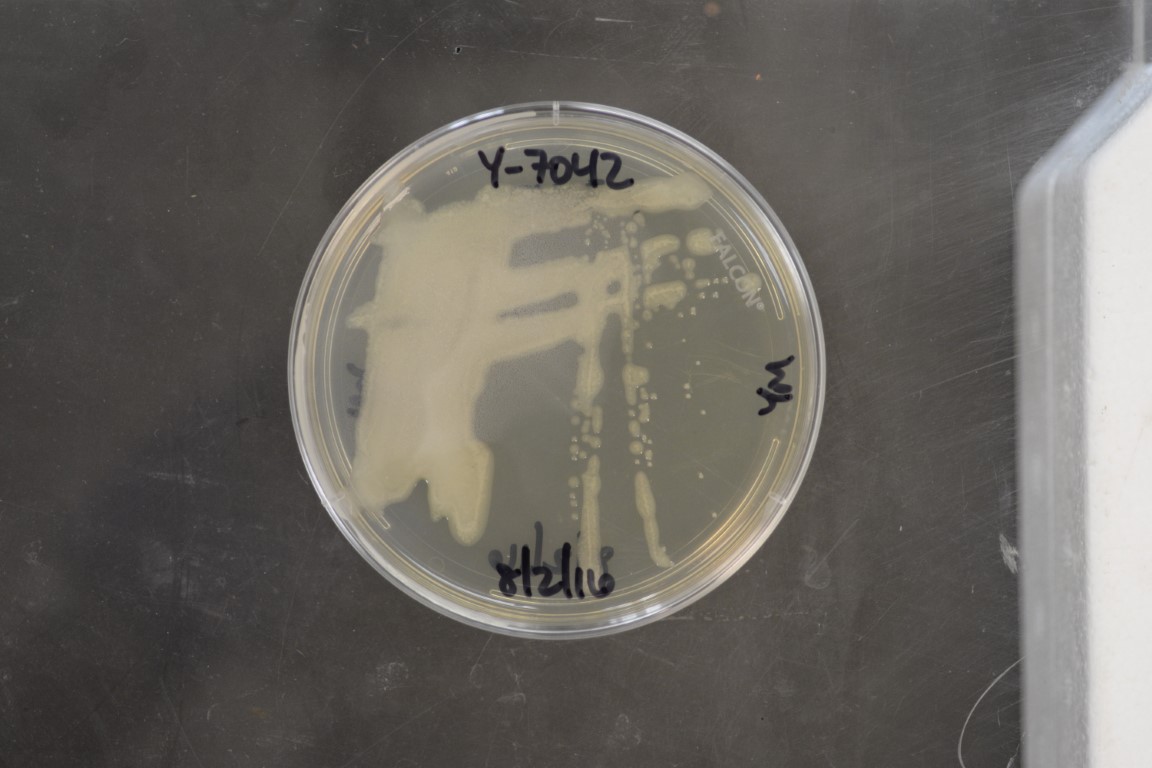

Lipomyces spencer-martinsiae
NRRL Y-7042(Type Strain)
Accession numbers in other collections:ATCC 44833=BCC 45250=CBS 5608=CCRC 21537=IFO 10376=IGC 4052=IP 56=JCM 5990=MUCL 39415=NRRL Y-11554=PYCC 4052
Source:W.Slooff,CBS,Delft,The Netherlands
Isolated from(substrate):SL,soil
Substrate location:Nigeria
Genetic info:Robnett PCR#824.GenBank:D1/D2(U84237),LSU(DQ518980),SSU(DQ519011),mito SSU(DQ496154),EF-1 alpha(DQ496132).
Growth media:Yeast Extract-Malt Extract-Peptone-Glucose(YM for yeasts)(number 6)
Optimum growth temperature:25C
Strain images:
NRRL_Y-7042_6.JPG

Comments:type strain of Lipomyces kononenkoae subsp.spencer-martinsiae